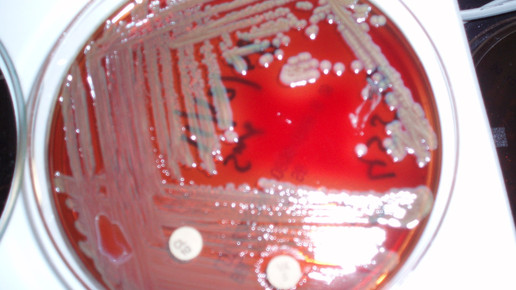

So testen Kliniken auf Resistenzen
Tritt im Krankenhaus eine Infektion auf, kann es schnell ernst werden. Denn viele Patienten sind geschwächt, die Erreger dagegen mitunter bereits gegen bestimmte Wirkstoffe resistent. In der Regel wird daher vor der Behandlung im Labor getestet, welches Mittel anschlägt.
Die Testung auf Antibiotika-Sensitivität im Labor erfolgt über einen Plattendiffusionstest (Antibiogramm). Dabei wird ein Abstrich auf eine Agar-Platte aufgebracht und bebrütet. Das Nährmedium wird mit kleinen Plättchen versetzt, die verschiedene Antibiotika enthalten. Je weiter die Wirkstoffe in den Agar diffundieren, desto stärker nimmt ihre Konzentration ab. Ist das Bakterium empfindlich gegenüber einem Antibiotikum, bildet sich ein Hemmhof um das entsprechende Plättchen. Die Größe des Hofes gibt dabei Auskunft über die Konzentration, die zur Wachstumshemmung benötigt wird.
Ein weiteres Verfahren ist die Analyse der Keime mittels Polymerasekettenreaktion (PCR). Hier wird das Genom des Bakteriums analysiert und auf eventuelle Resistenzgene untersucht. So kann relativ schnell eine Aussage darüber getroffen werden, ob der Erreger beispielsweise Beta-Lactamasen oder New-Delhi-Metalloproteinasen besitzt.
Bemerkt die Labordiagnostik einen multiresistenten Keim, ist das Klinikpersonal alarmiert. Der Patient wird isoliert und gegen die Erreger behandelt. Ein Großteil der Menschen trägt zum Beispiel methicillin-resistente Staphylococcus aureus-Bakterien (MRSA) in der Nase, ohne dass ein Krankheitsbild besteht. Fällt dies durch einen Abstrich auf, werde die Nase durch Octenidin beziehungsweise Mupirocin dekontaminiert, erklärt Krankenhausapotheker Dr. Martin J. Hug. Beide Stoffe könnten nur lokal eingesetzt werden.

APOTHEKE ADHOC Debatte